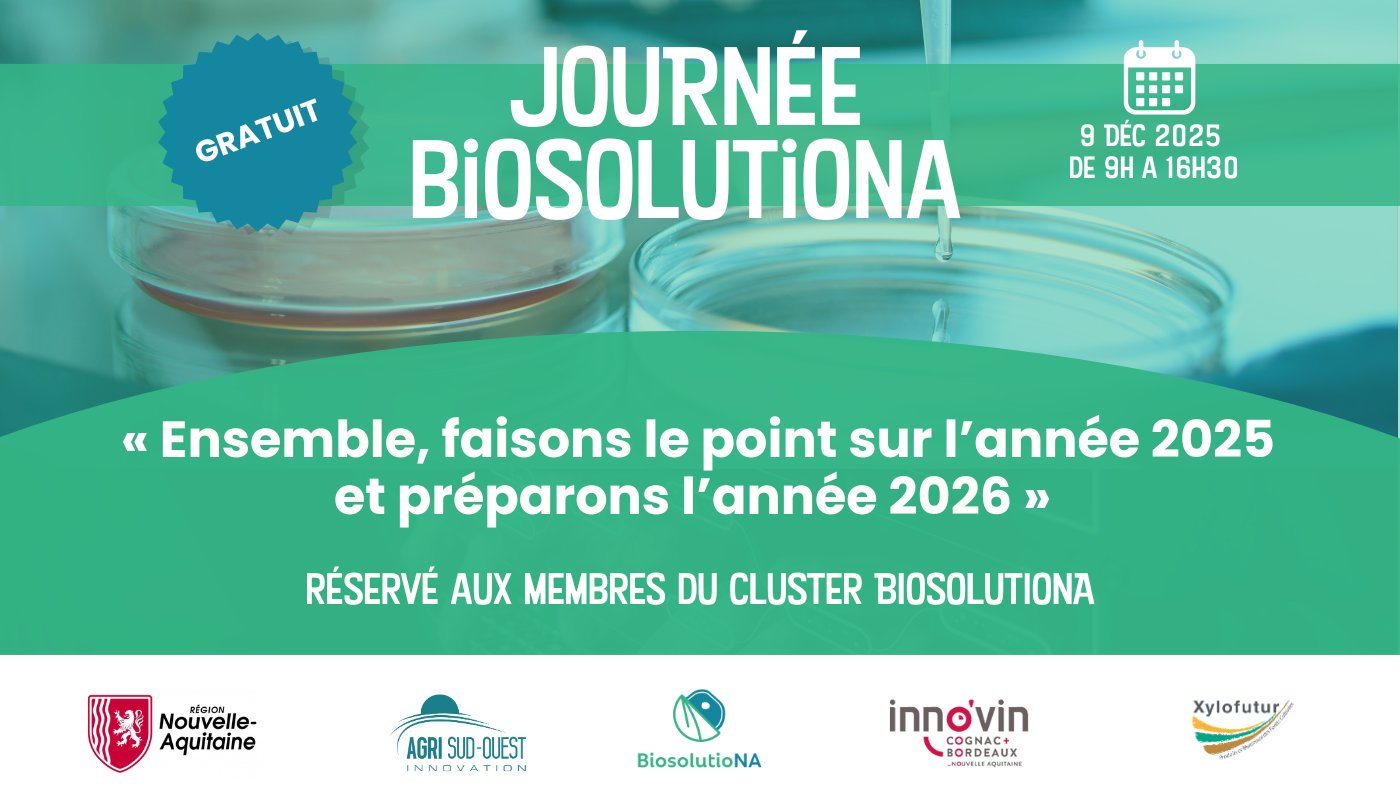

Journée BiosolutioNA : Ensemble clôturons l’année 2025 !
Journée BiosolutioNA : Ensemble clôturons l’année 2025 !
Journée BiosolutioNA : Ensemble clôturons l’année 2025 !
Journée BiosolutioNA : Ensemble clôturons l’année 2025 ! En partenariat avec Xylofutur et Innovin, Agri Sud-Ouest Innovation vous donne rendez-vous le mardi 9 décembre 2025 de 9h à 16h30 à Bordeaux.
Objectif : « Ensemble, faisons le point sur l’année 2025 et préparons l’année 2026 ».
Événement réservé aux membres du cluster BiosolutioNA.
Consultez le plan d’accès ici pour rejoindre la Délégation AFNOR Nouvelle-Aquitaine, 3 avenue Rudolf Diesel - Bât. B, 33700 Mérignac.
Parking gratuit sur place, Tram ligne A – arrêt Caroline d’Aigle